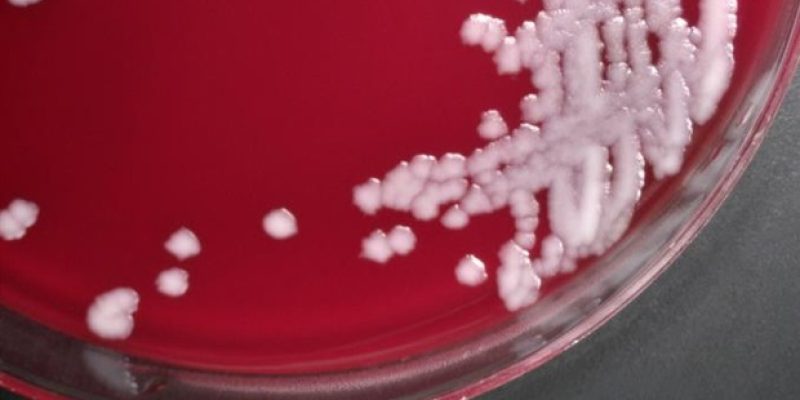
Ein gemeinsamer Entzündungsweg verwandelt Anthrax-Toxin in einen Killer

Foto: Getty ImagesDoncic erreichte den Meilenstein am Weihnachtstag dieses Jahres gegen die Suns. Er ging ins Spiel und benötigte nur 11 Punkte, um den Rekord aufzustellen. Mit 24 ist er viermaliger All-Star.Bob McAdoo war einer der besten Großschützen aller Zeiten und ein Spieler mit ...
READ MORE +